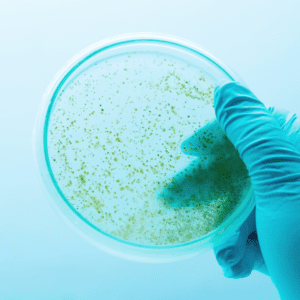

We look at the applications of genome-editing in agriculture, and the role...
Read more The future of genome editing in agriculture

Congress Center Basel, Switzerland, booth 28
We'll be in Basel for Future Labs Live, showing you how Automata is shaping the lab of tomorrow.
If you’re at Future Labs Live this year, come by booth 28 to meet the Automata team and see how we’re helping to shape the future of labs.
On Wednesday, at 11:30am CEST, Applications Engineering Lead, Axel Daïan, will be hosting a round table focused on building a truly collaborative lab space with automation. Join the discussion in Room Sydney.
Doug Rich, Head of Commercial, will also be presenting his talk: ‘Lab automation. Think bigger.’ at 3:00pm CEST in Room Singapore, which will prepare you with actionable insights on getting more from your lab automation equipment today.
Accelerating new drug discovery through automation.
Complete colony counting automation for environmental testing.
Complete automated workflow solution for ELISA assays.
Quality control in genomic workflows

Automating media exchange in cell culture workflows


We look at the applications of genome-editing in agriculture, and the role...
Read more The future of genome editing in agriculture
Learn how open integrated automation can transform translational research, helping labs to...
Read more Bench to bedside: what is translational research, and how can automation help?
Learn how open, integrated automation can streamline microbiology lab processes, overcome challenges...
Read more Automation in microbiology
Tips to help CROs and CDMOs when sourcing future-proofed automation solutions that...
Read more Tips for contract labs: sourcing future-proofed automation solutions

Meet us at stand 718 this May for SLAS Europe 2024. BOOK...
Read more SLAS Europe 2024

We’ll be at the Future Labs, Automation & Tech Summit; book a...
Read more Future Labs, Automation & Technology

Catch Automata at LRIG-NYC’s Spring Expo this May 16. BOOK A MEETING...
Read more LRIG-NYC

Team Automata will see you in Toronto for LRIG Canada, May 29....
Read more LRIG Canada

Book some time with Team Automata at LRIG Philly in PA. BOOK...
Read more LRIG Philly

It was great to see you at Midwest LRIG! GET IN TOUCH...
Read more Midwest LRIG

Flexibility is crucial for future-proofed automation solutions. Here are five reasons why
Read more Five reasons flexibility needs to be a standard feature of automation solutions

How can lab automation help ensure that the data we generate now...
Read more Creating a single source of truth for your lab

This blog explores why flexibility in lab automation is so difficult to...
Read more Tackling flexibility

Why is lab automation so hard to use? And why does it...
Read more Balancing usability and functionality

Discover how automation platforms like LINQ handle errors to improve trust and...
Read more Making error handling better

The Automata team have just returned from showcasing two amazing LINQ systems...
Read more Conference takeaways: SLAS 2024

Automata speak at eLabDiscovery Day, February 2024. CONNECT WITH CALUM DOHERTY eLabDiscovery...
Read more eLabDiscovery Day

Intelligent experiment scheduling can make or break productivity in a lab and...
Read more Dynamic replanning: a new way to schedule workflows and why it matters

Automata's top tips for getting the most out of your #SLAS24 experience...
Read more SLAS conference tips and Boston science tourism

Thanks for joining us at SLAS 2024 in Boston. BOOK A CHAT...
Read more SLAS 2024

Join us next week in Oxford for a free morning of educational...
Read more AltemisLab Oxford meeting November


The lab automation platform that removes bottlenecks and accelerates drug discovery at...
Read more Automation solutions for drug discovery

Since the last time we talked, Automata and our customers have achieved...
Read more From robot arms to automation platforms: the future of lab tech

We explore common problems in plus the advantages and disadvantages of plant...
Read more Plant tissue culture: how automation can help

See Team Automata in Cambridge, MA at LRIG New England’s event CONNECT...
Read more LRIG New England’s Fall Seminar and Exhibition

Automata's Director of Product Growth, Russ Green PhD, will be hosting a...
Read more Green Lab Symposium

Team Automata are at Future Labs Live USA, on booth 523 BOOK...
Read more Future Labs Live USA

Gene-editing technology such as CRISPR could be the future of agriculture. We...
Read more CRISPR in agriculture: applications, benefits & risks

Find out how open, integrated automation can accelerate the ELISA development process...
Read more Scaling up ELISA development with automation

Genomics is transforming the future of agriculture. Learn how open, integrated automation...
Read more Agrigenomics: the role of automation

See LINQ in action at The Francis Crick Institute BOOK A MEETING...
Read more Crick International Cancer Conference

Team Automata and LINQ at the Festival of Biologics, this October BOOK...
Read more Festival of Biologics

Meet Automata at Drug Discovery 2023, hosted by ELRIG UK BOOK A...
Read more Drug Discovery 2023

Discuss automating your lab with Automata at ASHG 2023 BOOK A MEETING...
Read more ASHG’s Annual Meeting


The lab automation platform that helps CROs stay flexible to changing workflows...
Read more Automation solutions for CROs

The Crick is now looking for a Senior Laboratory Scientist to work...
Read more Automata and The Francis Crick Institute seek molecular biologist for an exciting new project

We’re in Birmingham for ACGS’ Summer Conference BOOK A MEETING WITH US...
Read more ACGS Summer Conference

Proper reagent preparation is key to experimental success. Find out how automated...
Read more Preparing reagents: how automation can help

Automated, remote-operated cloud laboratories allow researchers to run experiments 24/7. We look...
Read more What are cloud labs?

Discover how automated cell culture incubators can scale your cell biology workflows,...
Read more Automated cell culture incubation

Discover how open, integrated automation can streamline common processes in clinical labs,...
Read more How to automate your chemistry lab

Find out how open, integrated automation can accelerate the ELISA validation process...
Read more ELISA assay validation: how automation can help

Automata and LINQ are at The Bioprocessing Summit. BOOK A DEMO AND...
Read more The Bioprocessing Summit

We’re in Boston for Lab Automators Ep. III CONNECT WITH BOBBY Register...
Read more Boston Lab Automators

Automata will be attending AACC in Anaheim, California to help labs realise...
Read more 2023 AACC Annual Scientific Meeting and Clinical Lab Expo

We're attending ASM Microbe to help labs discover how automation can transform...
Read more ASM Microbe 2023

We're attending European Human Genetics Conference 2023 to help labs discover how...
Read more European Human Genetics Conference 2023

Explore the value of reproducibility in the lab, and how automation can...
Read more How to ensure lab reproducibility with automation

How we reimagined the lab bench for automation.
Read more Five ways we redesigned the lab bench for automation

Meet LINQ and the Automata team at stand 76 BOOK A DEMO...
Read more Future Labs Live

Discover how lab turnaround time can be reduced through automation, without compromising...
Read more How to improve turnaround time in the lab

Discover how automation can facilitate repetitive maintenance of cell line processes, enhancing...
Read more Maintaining cell lines with automation

Discover the advantages of automated liquid handling in cell culture, from reduced...
Read more Unlocking the potential of 3D cell cultures with automation

From diagnosis to treatment, new technologies are revolutionising scientists' approach to cancer...
Read more Automation in cancer genome sequencing

Meet LINQ and the Automata team at booth 301 BOOK A DEMO...
Read more SLAS Europe 2023

Join us at stand 42 and find out about Automata LINQ Register...
Read more Bioprocessing Summit

By utilising the power of open, integrated automation solutions lab technicians can...
Read more Unlocking the power of people in your lab

By utilising the power of open, integrated automation solutions lab technicians can...
Read more How to unlock the space in your lab

Imagine what potential could look like for your science lab if you...
Read more Unlock the potential of your science lab with automation

Missed us at SLAS San Diego? There’s still time to book a...
Read more SLAS San Diego 2023

Team Automata will be at this year’s Festival of Genomics. Find us...
Read more Unlocking your lab’s potential at the Festival of Genomics

Sonia Jassi, Drug Discovery and Synthetic Biology Lead at Automata, examines how gene...
Read more Challenges of working with genetically edited cells

Discover how you can reduce time-intensive processes, improve data quality and optimise...
Read more Improving NGS library prep with automation

Discover how you can supercharge your lab’s productivity, increase efficiency and save...
Read more How to improve laboratory productivity

Learn how you can optimise common lab quality control processes through automation,...
Read more How to ensure quality control in a lab

Lab 4.0 technologies allow laboratories to unlock their potential through digital transformation...
Read more What is lab 4.0?

Discover the advantages of automated liquid handling in cell culture, from reduced...
Read more Benefits of automated liquid handling in cell culture

We’ll be at Stand 110 discussing how automation is shaping the labs...
Read more BioTechX: Data. AI. Precision. Innovation. For Pharma, Healthcare & Partners

The steps for finding the lab automation solution that's the right fit...
Read more Becoming a smart lab: the three stages

Automation is still widely underutilised in the lab space. Here are our...
Read more Four methods for enhancing automation in your lab

Come and see how we’re redefining microbiology automation. Come and learn more...
Read more Campden Bri: Hot topics in food microbiology on-site conference

How the lessons we learned from manufacturing automation can help supercharge your...
Read more Applying automation lessons from manufacturing in the lab

Integrating data from the offset and LEGO lab automation: Here’s what I...
Read more Industry insider: my takeaways from SmartLabs UK 2022

Russell Green, Director of Product Growth at Automata outlines the four biggest...
Read more The four biggest trends in lab automation this year

Find out what some of the biggest themes and challenges are within...
Read more 3 key themes from Future Food-Tech Alternative Proteins Summit

Cell culture labs are labour intensive which can contribute to a poor...
Read more How to better utilise staff in cell culture labs

Automating mammalian cell culture can improve the scale and quality of results...
Read more Quick automation wins in mammalian cell culture

Our round up of the latest innovations and trends in the lab...
Read more SLAS Europe 2022: five key trends in lab automation this year

As cell cultures become more advanced, optimising culture quality is more important...
Read more Improving cell culture quality

As demand for cell culture increases, labs are under pressure to scale...
Read more Scaling cell culture processes

Genomic sequencing will revolutionise healthcare over the next decade. We take a...
Read more Unlocking the potential of genomic sequencing

We look at what causes errors in biology lab experiments and how...
Read more Common sources of error in biology lab experiments
Manual colony counting is repetitive and error-prone, but, with automation, it can...
Read more Human error in colony counting in a clonogenic assay

Downtime in drug discovery labs delay an already long and complex process....
Read more How to reduce downtime in a drug discovery lab

With collating data never more important, automation offers a unique opportunity to...
Read more How automated labs can improve information gathering

Rapidly developing breakthrough treatments at pace is critical. We investigate the benefits...
Read more Investigating lab automation in early drug discovery

With the reliance on PCR testing set to continue, automation offers an...
Read more How automating labs can improve PCR testing capacity, accuracy and speed

Despite protections, human error in labs still leads to incorrect diagnostics and...
Read more How automation prevents human error in the laboratory


Investing in lab automation in 2022? Here are the best practices for...
Read more How to select the right lab automation partner

With the new COVID-19 variant on the rise across the globe, PCR...
Read more Omicron puts PCR testing back in the news. How can labs meet demand?

Explore the many methods diagnostics labs can employ to improve efficiency in...
Read more Seven steps for increasing efficiency in diagnostics

Government and industry have an opportunity to revolutionise diagnostics in the UK:...
Read more Diagnostic automation key for NHS to ‘build back better’

ab automation in diagnostics can help labs scale testing, improve speed and...
Read more How to automate diagnostics processes

Laboratory workflow automation links multiple lab automation technologies to automate entire diagnostic...
Read more What is laboratory workflow automation in diagnostic testing?

Lab automation technologies reduce the pressure on repetitive tasks, increase productivity and...
Read more The benefits of lab automation for diagnostic testing

Quality in lab diagnostics is critical. We explore methods of ensuring quality...
Read more Ensuring quality in laboratory diagnostics

The UK government’s U-turn on fit to fly PCR tests has brought...
Read more Is this the end of fit to fly COVID-19 PCR tests?

Read more Which lab processes can be automated today?